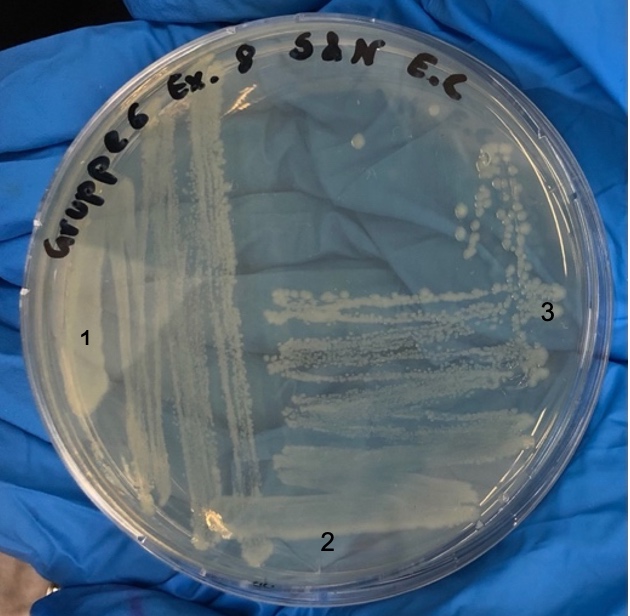

Activity
Mon
Wed
Fri
Sun
Jul
Aug
Sep
Oct
Nov
Dec
Jan
Feb
Mar
Apr
May
Jun
What is this?
Less
More
Memberships
SkooI Deutschland
2.3k members • Free
Skool Mastery (Kunden)
18 members • Free
Contributions
@narmin-said-omer-5287
Narmin, 28J, Salzburg
Active 564d ago
Joined Nov 29, 2024
Powered by